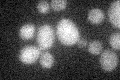
YGL198W
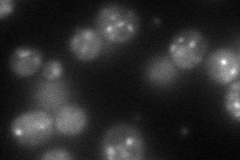
YGL198W
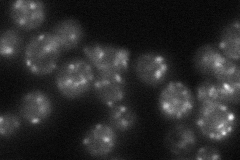
YGL198W

View description
Protein that interacts with Rab GTPases, localized to late Golgi vesicles; computational analysis of large-scale protein-protein interaction data suggests a possible role in vesicle-mediated transport
Localization:
Intensity:
Fold change:
Significance:
-
C’ GFP library in SD
below threshold14.63 -
N' NOP1pr-GFP in SD
punctate71.3903 -
N' TEF2pr-mCherry in SD

ER,punctate41.4544 -
N' NATIVEpr-GFP in SD
punctate45.5467 -
N' TEF2pr-VC and Cyto-VN in SD

punctate32.1069 -
C’ GFP library in SD+DTT

cytosol14.821.01No -
C’ GFP library in SD+H2O2

cytosol13.960.95No -
C’ GFP library in Starvation Media

cytosol17.871.22No -
C’ GFP library on the background of Pup2-DaMP

below threshold -
C’ GFP library on the background of CCT mutant

below threshold14.3960.9838No
